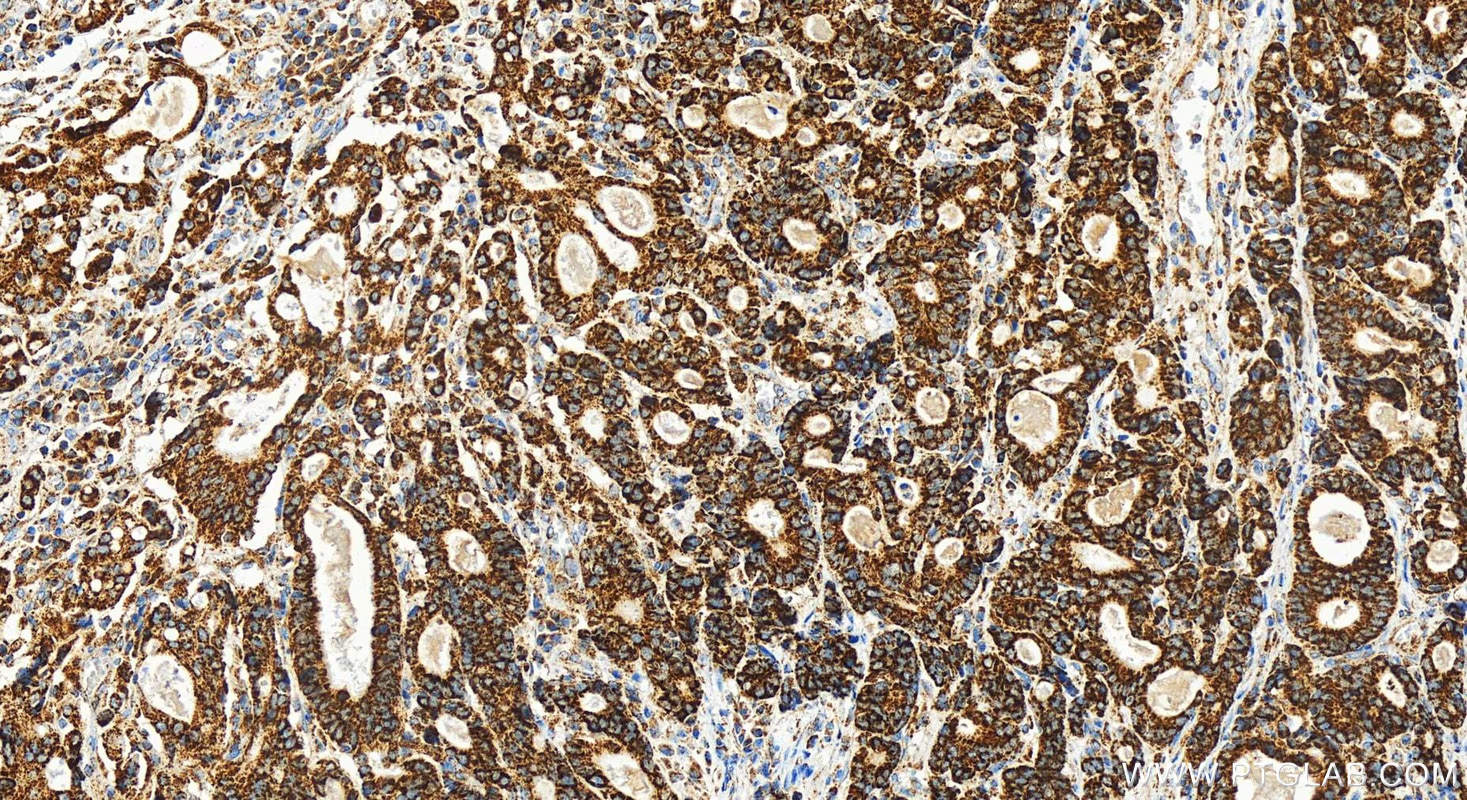
Immunohistochemical analysis of paraffin-embedded human stomach cancer tissue slide using 82957-2-RR (FDX1 antibody) at dilution of 1:400 (under 20x lens). Heat mediated antigen retrieval with Tris-EDTA buffer(pH9).

Various lysates were subjected to SDS PAGE followed by western blot with 82957-2-RR (FDX1 antibody) at dilution of 1:3000 incubated at room temperature for 1.5 hours.
Various lysates were subjected to SDS PAGE followed by western blot with 83654-3-RR (DLAT antibody) at dilution of 1:10000 incubated at room temperature for 1.5 hours.
Various lysates were subjected to SDS PAGE followed by western blot with 67298-1-Ig (LIAS antibody) at dilution of 1:3000 incubated at room temperature for 1.5 hours.
HepG2 cells were subjected to SDS PAGE followed by western blot with 67221-1-Ig (SLC31A1 antibody) at dilution of 1:20000 incubated at room temperature for 1.5 hours.
Various lysates were subjected to SDS PAGE followed by western blot with 67702-1-Ig (DLD antibody) at dilution of 1:5000 incubated at room temperature for 1.5 hours.
Various lysates were subjected to SDS PAGE followed by western blot with 68238-1-Ig (PDHB antibody) at dilution of 1:10000 incubated at room temperature for 1.5 hours.
HepG2 cells were subjected to SDS PAGE followed by western blot with 66119-1-Ig (PDH E1α antibody) at dilution of 1:20000 incubated at room temperature for 1.5 hours.
Various lysates were subjected to SDS PAGE followed by western blot with 85288-2-RR (ATP7B-Specific antibody) at dilution of 1:10000 incubated at room temperature for 1.5 hours.
HEK-293 cells were subjected to SDS PAGE followed by western blot with 83012-5-RR (GCSH antibody) at dilution of 1:10000 incubated at room temperature for 1.5 hours.
Various lysates were subjected to SDS PAGE followed by western blot with 12451-1-AP (DBT antibody) at dilution of 1:15000 incubated at room temperature for 1.5 hours.
Various lysates were subjected to SDS PAGE followed by western blot with 12855-1-AP (KGA/GAC antibody) at dilution of 1:15000 incubated at room temperature for 1.5 hours.
IP result of anti-PDH E1 Alpha (IP:66119-1-Ig, 4ug; Detection:66119-1-Ig 1:10000) with K-562 cells lysate 1820 ug.
IP result of anti-KGA/GAC (IP:12855-1-AP, 4ug; Detection:12855-1-AP 1:5000) with mouse brain tissue lysate 2400 ug.
Immunohistochemical analysis of paraffin-embedded human stomach cancer tissue slide using 82957-2-RR (FDX1 antibody) at dilution of 1:400 (under 20x lens). Heat mediated antigen retrieval with Tris-EDTA buffer(pH9).
Immunohistochemical analysis of paraffin-embedded human stomach cancer tissue slide using 83654-3-RR (DLAT antibody) at dilution of 1:500 (under 20x lens). Heat mediated antigen retrieval with Tris-EDTA buffer(pH9).
Immunohistochemical analysis of paraffin-embedded mouse brain tissue slide using 67298-1-Ig (LIAS antibody) at dilution of 1:1000 (under 10x lens). Heat mediated antigen retrieval with Tris-EDTA buffer (pH 9.0).
Immunohistochemical analysis of paraffin-embedded human liver cancer tissue slide using 67221-1-Ig (SLC31A1 antibody) at dilution of 1:2000 (under 40x lens). Heat mediated antigen retrieval with Tris-EDTA buffer (pH 9.0).
Immunohistochemical analysis of paraffin-embedded human liver cancer tissue slide using 67702-1-Ig (DLD antibody) at dilution of 1:500 (under 10x lens). Heat mediated antigen retrieval with Tris-EDTA buffer (pH 9.0).
Immunohistochemical analysis of paraffin-embedded mouse kidney tissue slide using 68238-1-Ig (PDHB antibody) at dilution of 1:1000 (under 40x lens). Heat mediated antigen retrieval with Tris-EDTA buffer (pH 9.0).
Immunohistochemical analysis of paraffin-embedded human liver tissue slide using 66119-1-Ig (PDH E1α antibody at dilution of 1:50(under 40x lens).
Immunohistochemical analysis of paraffin-embedded mouse liver tissue slide using 85288-2-RR (ATP7B-Specific antibody) at dilution of 1:2000 (under 40x lens). Heat mediated antigen retrieval with Tris-EDTA buffer (pH 9.0).
Immunohistochemical analysis of paraffin-embedded human stomach cancer tissue slide using 12451-1-AP (DBT antibody) at dilution of 1:1000 (under 10x lens). Heat mediated antigen retrieval with Tris-EDTA buffer (pH 9.0).
Immunohistochemical analysis of paraffin-embedded human gliomas tissue slide using 12855-1-AP (KGA/GAC antibody) at dilution of 1:200 (under 10x lens). Heat mediated antigen retrieval with Tris-EDTA buffer (pH 9.0).
Immunofluorescent analysis of (4% PFA) fixed HepG2 cells using FDX1 antibody (82957-2-RR, Clone: 230196E9 ) at dilution of 1:400 and CoraLite®488-Conjugated Goat Anti-Rabbit IgG(H+L) (SA00013-2), CL594-Phalloidin (red).
Immunofluorescent analysis of (4% PFA) fixed HepG2 cells using DLAT antibody (83654-3-RR, Clone: 240713C12 ) at dilution of 1:250 and CoraLite®488-Conjugated AffiniPure Goat Anti-Rabbit IgG(H+L) (SA00013-2), CL594-Phalloidin (red).
Immunofluorescent analysis of (4% PFA) fixed human liver cancer tissue using 67221-1-Ig (SLC31A1 antibody) at dilution of 1:100 and CoraLite488-Conjugated AffiniPure Goat Anti-Mouse IgG(H+L).
Immunofluorescent analysis of (4% PFA) fixed HeLa cells using PDHB antibody (68238-1-Ig, Clone: 2A7C10 ) at dilution of 1:1000 and Multi-rAb CoraLite® Plus 594-Goat Anti-Mouse Recombinant Secondary Antibody (H+L) (Cat.NO. RGAM004 ).
Immunofluorescent analysis of HepG2 cells using 66119-1-Ig (PDH E1α antibody) at dilution of 1:100 and Rhodamine-Goat anti-Mouse IgG.
Immunofluorescent analysis of (4% PFA) fixed paraffin-embedded mouse liver tissue using ATP7B-Specific antibody (85288-2-RR, Clone: 242827B3 ) at dilution of 1:400 and CoraLite®488-Conjugated Goat Anti-Rabbit IgG(H+L) (SA00013-2). Heat mediated antigen retrieval with Tris-EDTA buffer (pH 9.0).
Immunofluorescent analysis of (4% PFA) fixed HepG2 cells using DBT antibody (12451-1-AP) at dilution of 1:400 and CoraLite®488-Conjugated Goat Anti-Rabbit IgG(H+L), CL594-Phalloidin (red).
Immunofluorescent analysis of (-20°C Ethanol) fixed HeLa cells using KGA/GAC antibody (12855-1-AP) at dilution of 1:400 and CoraLite®488-Conjugated Goat Anti-Rabbit IgG(H+L) (SA00013-2), CL594-Phalloidin (red).
1x10^6 A431 cells were intracellularly stained with 0.4 ug FDX1 Recombinant antibody (82957-2-RR, Clone:230196E9) and CoraLite®488-Conjugated AffiniPure Goat Anti-Rabbit IgG(H+L) (SA00013-2)(red), or 0.4 ug Isotype Control (blue). Cells were fixed with 4% PFA and permeabilized with Flow Cytometry Perm Buffer (PF00011-C).
1x10^6 HepG2 cells were intracellularly stained with 0.25 ug DLAT Recombinant Antibody (83654-3-RR, Clone:240713C12) and APC-Conjugated AffiniPure Goat Anti-Rabbit IgG(H+L)(red), or 0.25 ug Isotype Control (blue). Cells were fixed with 4% PFA and permeabilized with Flow Cytometry Perm Buffer (PF00011-C).
1x10^6 HepG2 cells were intracellularly stained with 0.25 ug ATP7B-Specific Recombinant antibody (85288-2-RR, Clone:242827B3) and CoraLite®488-Conjugated Goat Anti-Rabbit IgG(H+L) (SA00013-2)(red), or 0.25 ug Rabbit IgG Isotype Control RecAb (98136-1-RR, Clone: 240953C9) (blue). Cells were fixed with 4% PFA and permeabilized with Flow Cytometry Perm Buffer (PF00011-C).
1X10^6 HeLa cells were intracellularly stained with 0.4 ug Anti-Human KGA/GAC (12855-1-AP) and CoraLite®488-Conjugated AffiniPure Goat Anti-Rabbit IgG(H+L) at dilution 1:1000 (red), or 0.4 ug rabbit IgG isotype control (blue). Cells were fixed with 4% PFA and permeabilized with Flow Cytometry Perm Buffer.